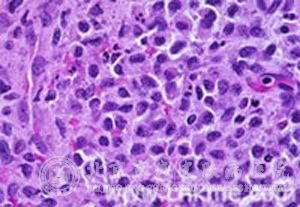

北京京城皮肤医院提供网络预约挂号服务
预约挂号热线:010-64888999
三级专科
医保定点
舒适环境
无假日
什么是泛发性扁平黄瘤病?黄瘤病的种类很多,所以在生活中患者很难区分自己患的是哪种类型,为了帮助患者区分黄瘤病,我们会在相关的文章里一一介绍,在这里我们为大家介绍一下泛发性扁平黄瘤病。那什么是泛发性扁平黄瘤病呢?
很多患者都不了解此病,所以对于这种现象北京京城皮肤医院会进行解决。
北京京城皮肤医院指出:泛发性扁平黄瘤病一般在在40~50岁后发病。较常见于眼睑周,可集中于上睑内侧,也可遍及整个上睑甚或整个眼睑。广泛的可对称地波及躯干和肢体以面、颈躯干上部和臂部为主。一般预后好应注意区别继发于网状内皮系统的黄瘤病。
以上是北京京城皮肤医院对泛发性扁平黄瘤病内容的相关介绍,是大家对此有了初步的了解,为了能够让大家了解更多,我们提供了挂号的方式,这样就能够更的帮助患者了解。
推荐阅读:什么叫散播性黄瘤病?
推荐阅读:原发性高脂蛋白性黄瘤病的类型有哪些?
推荐阅读:原发性非高脂蛋白性黄瘤病的种类有哪些?
推荐阅读:结节性黄瘤对患者的危害